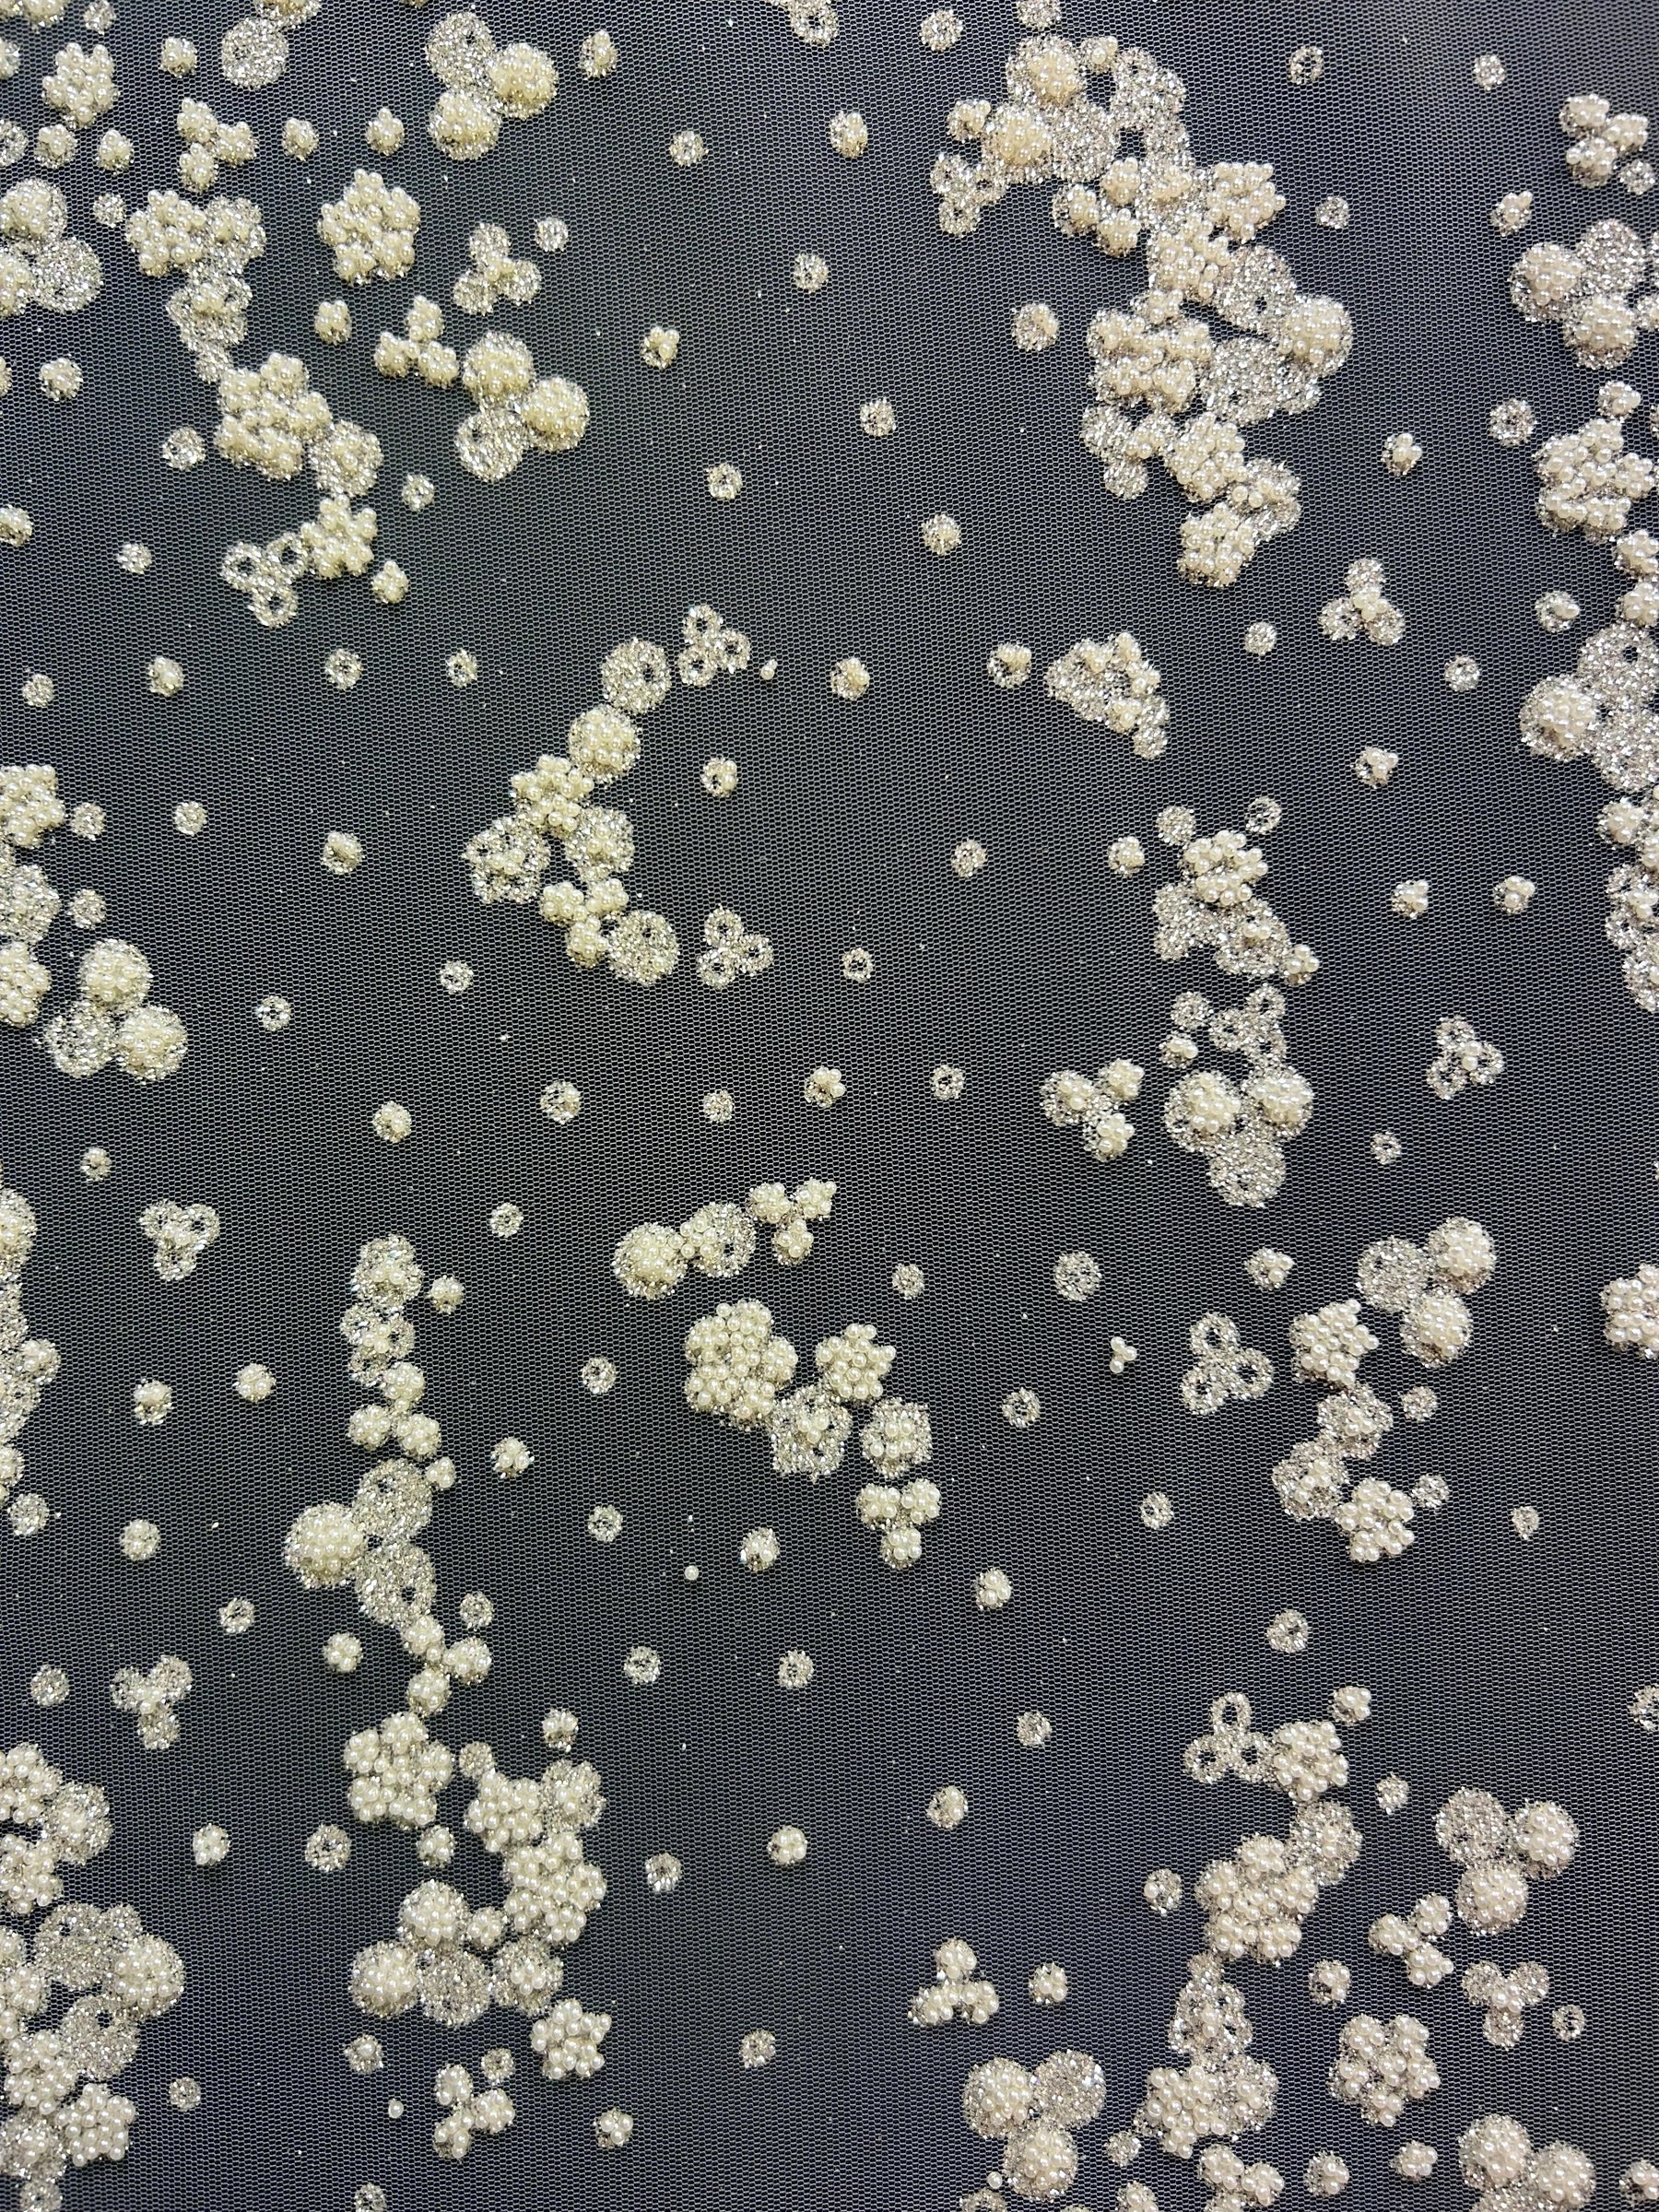

Elfenbeinfarbene Glitzerspitze - Breda
Suchen Sie Stoffmuster ? Fügen Sie unten ein Elfenbeinfarbene Glitzerspitze - Breda -Muster zu Ihrer Tasche hinzu. Ihre ersten beiden Muster sind kostenlos.
✨ Breda – Elfenbeinfarbener Glitzer und perlenbesetzte Blumenspitze
Breda ist eine zarte und schillernde Spitze, die Glitzer und kleine Perlen zu einem zarten Blumenmotiv auf transparentem Tüll kombiniert. Mit ihrem zierlichen Design und der großzügigen Breite von 156 cm (61 Zoll) sowie zusätzlichen 5–10 cm glattem Tüll auf jeder Seite bietet Breda Schönheit und Flexibilität für Ihre kreativen Projekte.
Diese Spitze wird mit einer speziellen Verzierungstechnik gefertigt, die auch in unseren Panopolis- und Sharman -Designs zum Einsatz kommt und Ihnen eine gleichbleibende Qualität über alle Stile hinweg bietet. Ob Brautkleider, Abendgarderobe oder Couture-Accessoires – Breda bietet Ihnen ein hervorragendes Preis-Leistungs-Verhältnis, ohne Kompromisse bei Glanz und Eleganz einzugehen.
🌸 Produkthighlights :
-
Design: Glitzer- und Perlencluster in Blumenarrangements
-
Breite: 156 cm (61") + 5–10 cm glatte Tüllränder
-
Finish: Weicher elfenbeinfarbener Tüll mit eleganter Verzierung
-
Verfügbarkeit: Auf Lager ohne Mindestbestellwert
-
Lieferung: Schneller weltweiter Versand
Für dieses Produkt liegen keine Kundenfragen vor. Seien Sie der Erste, der eine Frage stellt!
- Faserzusammensetzung: Polyamide with glitter
- Gewicht pro Laufmeter (GSM): NA
- Breite (cm): 156
- Herkunftsland: Turkey
Pflegehinweise
- Nur chemische Reinigung
Unsere Produkte sind größtenteils auf Lager und werden bei Bestellung vor 14:00 Uhr (GMT) noch am selben Werktag versandt. Einige Produkte müssen gefärbt werden, was in der Regel 2 Werktage dauert.
Sollte etwas nicht vorrätig sein, machen wir Sie darauf aufmerksam und nennen Ihnen einen voraussichtlichen Versandtermin.
Die Lieferung der Bestellung hängt von Ihrem Standort ab und wird beim Bezahlen angezeigt. Lesen Sie unsere vollständigen Lieferbedingungen .
Wir hoffen sehr, dass Sie mit Ihrer Bestellung zufrieden sind und empfehlen Ihnen, vor der Massenbestellung Muster zu bestellen, wenn Sie noch nicht bei uns bestellt haben.
Voll- und Teilstücke können innerhalb von 14 Tagen zurückgenommen und gutgeschrieben werden. Für angegebene Mengen wird eine Gebühr von 50 % erhoben. Lesen Sie unsere vollständigen Rückgabebedingungen.